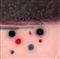

Asta N. 35 – Arte Moderna e Contemporanea Prima Sessione - dal lotto 1 al lotto 105
martedì 21 marzo 2017 ore 18:00 (UTC +01:00)
DENIS BOWEN 1921 - 2006 Advancing planets, 1969 Tecnica mista su tela, cm....
DENIS BOWEN 1921 - 2006 Advancing planets, 1969 Tecnica mista su tela, cm. 100 x 100 Firmato e datato sul retro Prov. Collezione Privata